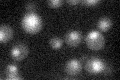
YDR473C
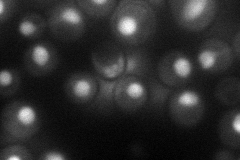
YDR473C
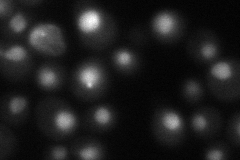
YDR473C
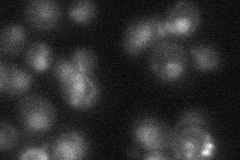
YDR473C

View description
Splicing factor, component of the U4/U6-U5 snRNP complex
Localization:
Intensity:
Fold change:
Significance:
-
C’ GFP library in SD
nucleus22.81 -
N' NOP1pr-GFP in SD
nucleus52.8767 -
N' TEF2pr-mCherry in SD
nucleus44.9236 -
N' NATIVEpr-GFP in SD
nucleus26.5896 -
N' TEF2pr-VC and Cyto-VN in SD

nucleus30.6514 -
C’ GFP library in SD+DTT

nucleus24.091.05No -
C’ GFP library in SD+H2O2

nucleus21.20.92No -
C’ GFP library in Starvation Media

nucleus22.540.98No -
C’ GFP library on the background of Pup2-DaMP

nucleus -
C’ GFP library on the background of CCT mutant

nucleus25.51261.11798No
